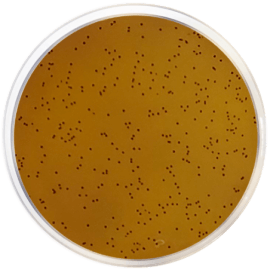
main product photo

Close
KF STREPTOCOCCAL AGAR with BCP 500 grams/bottle
SKU
CDL/1101
Brand
CONDALAB
Pre-order (Deliver in 8 to 12 weeks)
KF Streptococcal Agar with Bromocresol Purple is a selective medium for the isolation and enumeration of fecal enterococci in water, foodstuffs and other materials, according to the formula developed by Kenner, Clark and Kabler.
It is used for the plate count of enterococci in water samples and for determining the presence of Enterococcus faecalis in milk and its derivatives, as well as in other foods. The isolation and enumeration of fecal enterococci is made according to APHA for the examination of water (1998) and foodstuffs (1992).
Peptone mixture provides nitrogen, vitamins, minerals and amino acids essential for growth. Yeast extract is a source of vitamins, particularly of the B-group. Maltose and Lactose are the fermentable carbohydrates as carbon and energy sources. Sodium glycerophosphate is a buffering agent. Sodium azide is a selective agent that inhibits Gram-negative bacteria. Sodium chloride supplies essential electrolytes for transport and osmotic balance. Bromocresol purple is a pH indicator. Bacteriological agar is the solidifying agent.
The addition of TTC 1% Supplement(2,3,5 Trypheniltetrazolium chloride) allows fecal enterococci to develop a red color as the result of the reduction of tetrazolium to formazan, an insoluble red pigment, by actively growing microbial cells.
KF Streptococcal Agar with Bromocresol Purple is a selective medium for the isolation and enumeration of fecal enterococci in water, foodstuffs and other materials, according to the formula developed by Kenner, Clark and Kabler.
It is used for the plate count of enterococci in water samples and for determining the presence of Enterococcus faecalis in milk and its derivatives, as well as in other foods. The isolation and enumeration of fecal enterococci is made according to APHA for the examination of water (1998) and foodstuffs (1992).
Peptone mixture provides nitrogen, vitamins, minerals and amino acids essential for growth. Yeast extract is a source of vitamins, particularly of the B-group. Maltose and Lactose are the fermentable carbohydrates as carbon and energy sources. Sodium glycerophosphate is a buffering agent. Sodium azide is a selective agent that inhibits Gram-negative bacteria. Sodium chloride supplies essential electrolytes for transport and osmotic balance. Bromocresol purple is a pH indicator. Bacteriological agar is the solidifying agent.
The addition of TTC 1% Supplement(2,3,5 Trypheniltetrazolium chloride) allows fecal enterococci to develop a red color as the result of the reduction of tetrazolium to formazan, an insoluble red pigment, by actively growing microbial cells.
| Brand | CONDALAB |
|---|
Write Your Own Review

Validate your login